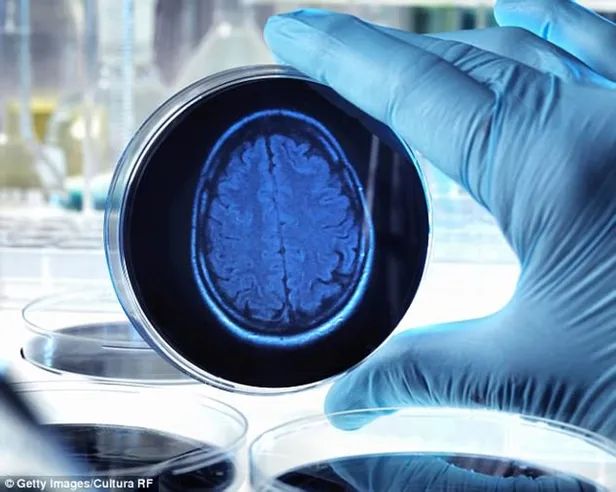
Uzman isim unutkanlığa karşı 3 altın baharatı açıkladı! Fil hafızası için 1 çay kaşığı yeterli

Uzman isim unutkanlığa karşı 3 altın baharatı açıkladı! Fil hafızası için 1 çay kaşığı yeterli
Günümüzde, yoğun tempolu yaşam tarzı ve bilgi bombardımanı altında gençler arasında unutkanlık sorunları daha yaygın hale gelmiştir. Bu konuda önemli bir figür olan Prof. Dr. Osman Müftüoğlu, güçlü bir bellek oluşturmanın önemine vurgu yaparak, bazı besinlerin hafıza problemlerine karşı etkili olabileceğini belirtiyor. Özellikle gençler arasında unutkanlık sorunlarına karşı önerdiği üç baharat, bu kategoride öne çıkıyor.
Türk mutfağının vazgeçilmezleri arasında yer alan baharatlar, sadece lezzet katmanın ötesinde çeşitli sağlık faydalarına da sahip. Türk mutfağının zengin baharat çeşitleri, bilinmeyen farklı sorunlara iyi gelme potansiyeli taşıyor. Araştırmalar, baharatların anti-inflamatuar, antimikrobiyal ve antioksidan özelliklere sahip olduğunu göstermektedir. Dolayısıyla, Türk mutfağının bu zengin baharatları sadece yemeklere lezzet katmakla kalmayıp aynı zamanda sağlık açısından da birçok olumlu etkiye sahip olabilir.
Günümüzde gençler arasında hafıza sorunları yaşayan bireylerin sayısında artış gözlemleniyor. Bu sorunlar genellikle ileri yaşlarda ortaya çıkan hafıza problemleriyle ilişkilendirilse de, genç yaşlarda da giderek daha sık görülmeye başlamıştır.
Prof. Dr. Osman Müftüoğlu'nun Baharat Tavsiyeleri

Sağlık konusunda sosyal medyada birçok tavsiye sunan Prof. Dr. Osman Müftüoğlu, güçlü bir bellek oluşturmanın anahtarının 3 baharat olduğunu belirtiyor. Bu baharatlar arasında yer alan zerdeçal, safran ve kimyonun, yapılan araştırmalara göre beyin fonksiyonlarını destekleyerek hafıza problemlerine karşı koruyucu bir etki gösterebileceği ifade edilmektedir.
Zerdeçalın Beyin İyileşmesinde Rolü
Alman bilim adamlarının yaptığı araştırmalara göre, zerdeçalın içeriğindeki bir madde, beyin iyileşmesinde etkili bir rol oynayabilir. Zerdeçalın beyindeki sinir hücrelerinin gelişimine katkıda bulunduğu belirtilirken, bu baharatın beyini koruma özelliğine sahip olduğu ortaya çıkmıştır.
Günlük Zerdeçal Tüketimi ve Beyin Fonksiyonları

Araştırmacılara göre, günde 1 çay kaşığı zerdeçal tüketmek, beyin fonksiyonlarının korunmasına yardımcı olabilir. Zerdeçalın yaşlanmaya bağlı beyin fonksiyonlarında bozulmayı azalttığı ve beyin iyileşmesine destek olduğu ifade edilmektedir.
📌Not: Bu önerilen baharatları kullanmadan önce, özellikle var olan herhangi bir sağlık sorununuz varsa veya daha fazla bilgi almak istiyorsanız, bir sağlık profesyoneli veya doktora danışmanız önemlidir. Her bireyin sağlık durumu farklı olduğundan, herhangi bir takviye veya baharat kullanımına başlamadan önce uzman görüşü almak güvenli bir yaklaşım olacaktır.
Gençlerde Hafıza Problemlerinin Altındaki Sebepler

Gençlerin yaşantısını olumsuz etkileyen hafıza sorunları, çeşitli sebeplere dayanmaktadır. Uyku problemleri, vitamin eksiklikleri ve depresyon gibi sağlık sorunları gençlerdeki hafıza problemlerinin temel nedenlerindendir. Ayrıca, teknolojik aletlerin yaygın kullanımı da bu durumu etkileyen bir faktördür.
Hafıza Sorunlarını Giderme Yolları

Genç yaşlarda görülen hafıza sorunlarının önüne geçmek için uygulanabilecek basit yöntemler bulunmaktadır. Düzenli kitap okuma, uyku düzeninin optimize edilmesi, dengeli beslenme alışkanlıkları edinme ve teknolojik alet kullanımının kontrol altına alınması, hafıza sorunlarını hafifletmede etkili faydalar sağlayabilir. Ayrıca, uzmanlar tarafından önerilen günlük su tüketimi ve düzenli egzersiz de gençlerin hafıza sağlığını destekleyebilir.
GÜNÜN MANŞETLERİ İÇİN TIKLAYIN